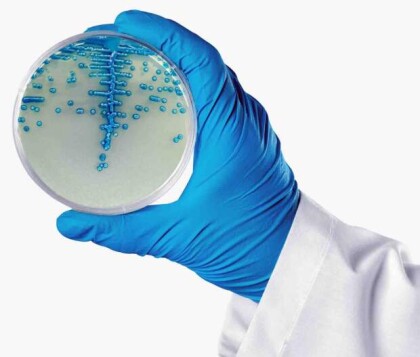

Doença é uma resposta inflamatória exagerada que traz graves complicações ao organismo; vigilância hospitalar evita que pacientes internados desencadeiem a doença.
A cada ano, 11 milhões de pessoas morrem em todo o mundo em decorrência da sepse, segundo informações da Organização Mundial da Saúde (OMS). No Brasil, há cerca de 400 mil casos de sepse em adultos anualmente, resultando em aproximadamente 240 mil óbitos por ano. Entre as crianças, o número de casos chega a 42 mil. Esses números indicam que o Brasil tem uma taxa de mortalidade significativamente mais alta do que a observada em muitos países desenvolvidos, de acordo com o Ministério da Saúde. Para conscientizar sobre a doença, foi criado o Dia Mundial da Sepse, comemorado em 13 de setembro.
Conhecida também como infecção generalizada, a sepse é uma resposta inflamatória exagerada que pode levar a disfunção orgânica e afetar vários órgãos. De acordo com a Dra. Lauriane Carneiro, médica intensivista do Hospital VITA, o quadro pode se originar frente a um vírus, bactéria, fungo ou protozoário presente no organismo e que o sistema imunológico tenta evitar.
Infecções como pneumonia, infecções abdominais e urinárias são frequentemente responsáveis por desencadear a sepse. Apesar de ser uma doença silenciosa e de difícil diagnóstico, em parte dos quadros alguns sintomas podem surgir. Kamila Gontijo de Oliveira, supervisora comercial, foi uma dessas pessoas que contraiu sepse, em duas ocasiões distintas, em 2021 e 2023. “Tive sintomas semelhantes as duas vezes. Na primeira vez, senti dor nas costas, que parecia uma crise renal. Fiquei alguns dias recebendo soro e medicação intravenosa devido à fraqueza intensa”, relata.
A supervisora descreve a demora para obter um diagnóstico conclusivo: “Na primeira vez, demorei para ser diagnosticada, pois passei por atendimentos superficiais. Na segunda, comecei o dia com dor nas costas e foi se agravando durante o dia. Fui para o hospital e logo fiz exame de sangue e ressonância. Neste momento, já fui informada que ficaria internada, pois estava com princípio de sepse. Fiquei internada por três dias, tomando antibióticos fortes e outras medicações intravenosas. Após a internação continuei tomando remédios por mais dez dias”, lembra.
Foco da infecção é essencial para o tratamento
Os sintomas variam conforme a gravidade da doença e o local da infecção. Alguns pacientes podem apresentar febre ou hipotermia, dificuldade para respirar, taquicardia, calafrios, baixa produção de urina, agitação e confusão mental. “Se a sepse tiver origem pulmonar (como na pneumonia), é provável que o paciente apresente sintomas respiratórios adicionais, como tosse e falta de ar. Se o foco for o sistema nervoso central, às vezes baixa o nível de consciência, o paciente fica mais sonolento, agitado, confuso e até com crise convulsiva. Os sintomas vão depender de onde essa infecção começou”, explica a médica intensivista.
A médica ainda esclarece que o diagnóstico funciona em etapas. Ou seja, quando há uma suspeita de infecção, o foco deve ser procurado. “Sabendo do foco eu imagino quais bactérias são mais comuns naquele local e começa um antibiótico empírico. Os exames pedidos são para tentar diagnosticar se esse paciente só tem uma infecção ou ele está desenvolvendo sepse”. Os exames frequentemente solicitados incluem testes de marcadores inflamatórios, como leucócitos elevados e proteína C-reativa, além de avaliações da função renal e eletrólitos, bilirrubina e exames de imagem como raio-x de tórax e análise parcial de urina.
Identificar o foco da infecção é fundamental para o tratamento, pois determina o uso de antibióticos específicos e a duração do tratamento, que pode variar conforme o tipo de bactéria ou vírus. Dra. Lauriane Carneiro ainda ressalta que a duração do tratamento pode depender de outros fatores. “Tem infecção que a gente pode tratar em três dias, já outras precisam de meses. Então, depende da gravidade das complicações, do paciente, da resposta terapêutica e da resposta ao tratamento. Precisamos do diagnóstico, do foco e ver se tem complicações ou não com o organismo de cada paciente”.
Vigilância hospitalar evita que pacientes internados desencadeiam sepse
A sepse é a principal causa de mortes em Unidades de Terapia Intensiva (UTIs), e manter um ambiente hospitalar controlado é essencial para prevenir a propagação de infecções entre os pacientes. A médica intensivista enfatiza que há muitos pacientes internados com bactérias multirresistentes e, por isso, é importante ter um bom controle interno.
“O ideal é a gente ter um controle interno de infecção hospitalar e sempre orientar em relação à higiene das mãos antes e após tocar no paciente e fazer uma educação continuada sempre com os bundles (medidas preventivas). Por exemplo, os pacientes que estão em UTI e usam dispositivos invasivos como a sonda vesical de demora (catéter) ou estão em ventilação mecânica, com eles temos todo um protocolo que deve ser seguido para a gente tentar diminuir as infecções relacionadas”, explica a Dra. Lauriane Carneiro.
Uma das estratégias para manter esse controle é realizar testes no ambiente hospitalar. A Advagen Biotech, especializada em microbiologia, oferece meios de cultura para monitorar e controlar a presença de microrganismos em ambientes hospitalares. “No Dia Mundial da Sepse, é crucial reforçar a importância da vigilância microbiológica para identificar rapidamente os patógenos causadores dessa condição. A Advagen oferece uma linha completa de meios de cultura, que são ferramentas essenciais para garantir diagnósticos rápidos e precisos, ajudando os médicos a implementar tratamentos mais eficazes e a melhorar o prognóstico dos pacientes”, destaca Jéssika Silva, Assessoria Científica da Advagen.
Entre os meios de cultura oferecidos pela Advagen estão: o Ágar Cromogênico KPC, que detecta e diferencia bactérias Gram-negativas produtoras de KPC, responsáveis por infecções como pneumonia, infecções urinárias, de sangue e gastrointestinais; o Ágar Cromogênico ESBL, que identifica rapidamente bactérias Gram-negativas produtoras de beta-lactamases, como E. coli, o Ágar Cromogênico MRSA, que detecta Staphylococcus aureus, causador de infecções de pele; e o Ágar Cromogênico VRE, que identifica Enterococos resistentes à vancomicina, causadores de várias infecções, incluindo do trato urinário.
De: DePropósito Comunicação de Causas | Por: Jéssica Amaral

Não serão publicados comentários com xingamentos e ofensas ou que incitem a intolerância ou o crime. Os comentários devem ser sobre o tema da matéria e sobre os comentários que surgirem. As mensagens que não atendam a essas normas serão deletadas. Os que transgredirem essas normas poderão ter interrompido seu acesso a este veículo.